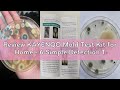
Review KAYENQO Mold Test Kit for Home - 6 Simple Detection Tests,Test HVAC System,Home Surfaces,&amp;Ind

- Популярные видео
- Авто
- Видео-блоги
- ДТП, аварии
- Для маленьких
- Еда, напитки
- Животные
- Закон и право
- Знаменитости
- Игры
- Искусство
- Комедии
- Красота, мода
- Кулинария, рецепты
- Люди
- Мото
- Музыка
- Мультфильмы
- Наука, технологии
- Новости
- Образование
- Политика
- Праздники
- Приколы
- Природа
- Происшествия
- Путешествия
- Развлечения
- Ржач
- Семья
- Сериалы
- Спорт
- Стиль жизни
- ТВ передачи
- Танцы
- Технологии
- Товары
- Ужасы
- Фильмы
- Шоу-бизнес
- Юмор
Review SIKE PWS450 Patient Weight Scale Kit for Lift, Universal Scale With 6-Point Sling Bar Spreade
👉🏼Check out the full review: https://www.essentialgrade.com/sike-pws450-patient-weight-scale-kit-with-lift-sling-review-the-definitive-solution-for-accurate-home-patient-monitoring/
SIKE PWS450 Patient Weight Scale Kit for Lift, Universal Scale With 6-Point Sling Bar Spreader Bar,
DISCLAIMER: This video may contain copyrighted material, the use of which has not always been specifically authorized by the copyright owner. We are making such material available in our efforts to advance understanding of the product. We believe this constitutes a "fair use" of any such copyrighted material.
Copyright Disclaimer Under Section 107 of the Copyright Act 1976, allowance is made for "fair use" for purposes such as criticism, comment, news reporting, teaching, scholarship, and research. Fair use is a use permitted by copyright statute that might otherwise be infringing. Non-profit, educational or personal use tips the balance in favor of fair use.
Видео Review SIKE PWS450 Patient Weight Scale Kit for Lift, Universal Scale With 6-Point Sling Bar Spreade канала Essential Grade TV
SIKE PWS450 Patient Weight Scale Kit for Lift, Universal Scale With 6-Point Sling Bar Spreader Bar,
DISCLAIMER: This video may contain copyrighted material, the use of which has not always been specifically authorized by the copyright owner. We are making such material available in our efforts to advance understanding of the product. We believe this constitutes a "fair use" of any such copyrighted material.
Copyright Disclaimer Under Section 107 of the Copyright Act 1976, allowance is made for "fair use" for purposes such as criticism, comment, news reporting, teaching, scholarship, and research. Fair use is a use permitted by copyright statute that might otherwise be infringing. Non-profit, educational or personal use tips the balance in favor of fair use.
Видео Review SIKE PWS450 Patient Weight Scale Kit for Lift, Universal Scale With 6-Point Sling Bar Spreade канала Essential Grade TV
Комментарии отсутствуют
Информация о видео
13 ч. 8 мин. назад
00:00:05
Другие видео канала